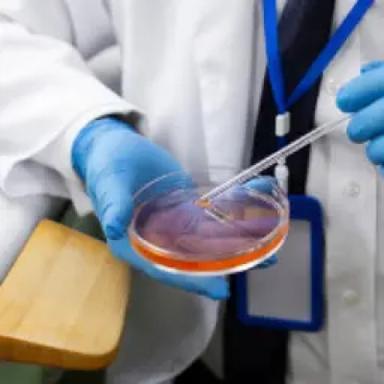
Anthelmintics

Days
Hours
Minutes
Seconds
Parasiticides are veterinary medications that treat and prevent parasites in animals, including fleas, ticks, lice, and worms. They are available in various forms, including tablets, collars, and topical solutions. These are essential for pet health, and veterinarians must prescribe them to pet owners as excessive use can have negative consequences.
History and Evolution
- Early Egyptians: Parasites have evolved long before humans and animals, and early Egyptian writings mention tapeworms and roundworms.
- 17th Century: Francesco Redi and Antonie van Leeuwenhoek studied parasites closely, establishing early parasitology.
- 20th century: In the 1980s, the development of chemical compounds blurred the traditional distinction between endo- and ectoparasiticides in veterinary medicine.
Types
Here are some common types of parasiticid...